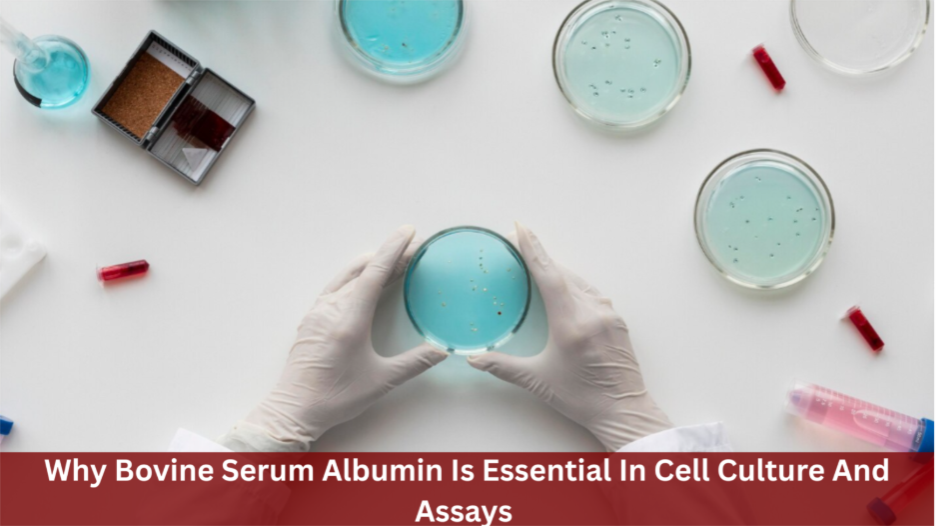
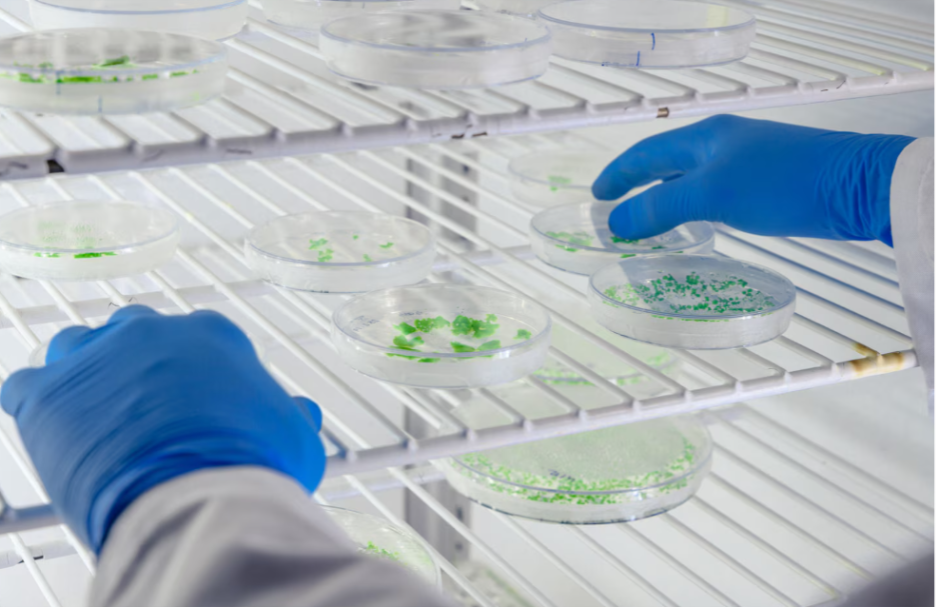

Why Bovine Serum Albumin Is Essential In Cell Culture And Assays
Cell culture and assay procedures demand consistent conditions, but even most experiments suffer from unstable proteins, inconsistent cell responses, and ambiguous assay signals. These problems are common even when protocols are followed carefully, which makes troubleshooting tricky and time-consuming.
In the long run, these inconsistencies compromise data reliability and delay research. In order to overcome these problems, researchers turn to the use of particular proteins that assist stability and regulation in experimental systems.
Bovine Serum Albumin has a pivotal role in enhancing reliability in both cell culture and assay studies. This article describes how Bovine Serum Albumin enhances protein stability, cell viability, assay precision, and reproducibility in contemporary laboratory processes.
1. Protein Stability Under Experimental Stress

Protein instability is one of the leading factors contributing to experimental inconsistencies. Exposure to environmental changes like temperature variations, mechanical forces, and surface exposure can alter the protein structure and decrease biological activity.
Under such circumstances, Bovine Serum Albumin is necessary since it is a stabilizing carrier protein that ensures that delicate biomolecules are safe under stress. Bovine Serum Albumin inhibits aggregation and structural degradation by binding exposed hydrophobic regions.
This protective measure enables enzymes, antibodies, and growth factors to be functional during experimental processes. Also, it helps buffer proteins during the repetition of handling and the prolonged incubation period. Consequently, experiments exhibit better reproducibility, especially in processes that require long durations of protein activity.
2. Cell Health Support in Culture Systems
The cell behavior and stability of the molecular environment require a healthy environment to aid in the use of energy, communication, and structure. This balance can be disrupted, leading to cells becoming stressed, and this influences the way they grow and react to experiments.
Bovine Serum Albumin assists in maintaining the health of cells as it transfers fatty acids, lipids, and hormones in a regulated manner. These molecules assist in the maintenance of cell membranes and normal energy processes, enabling the cells to address the normal functioning of cells in a predictable manner.
Further, it lowers stress within culture systems by complexing undesired compounds and metabolic waste. This reduces the exposure of cells to damaging agents and promotes the maintenance of normal cell shape with time. Consequently, cell cultures also become more stable, particularly under serum-reduced or long-term culture conditions.
3. Assay Accuracy Through Background Control
Clear signals and controlled interactions between molecules are some of the requirements of reliable assay results. Nonetheless, proteins tend to stick on assay surfaces in unwanted ways that increase background noise and complicate the interpretation of results.
Bovine Serum Albumin aids in addressing this issue by masking nonspecific binding sites and preventing the adhesion of proteins to sites they are not meant to. This makes assay surfaces cleaner, as well as lowering signal distortion.
It reduces the background interference, which simplifies the process of detecting and measuring the true signal. This results in a higher precision of the results and enhances consistency across experiments.
Improved background control also contributes to making sure that the repeatability of assays is possible and that this ensures that datasets can be validated and compared across different workflows.
4. Reduction of Nonspecific Molecular Binding
Experimental accuracy can be undermined by uncontrolled molecular interactions, which result in misleading results. Proteins may attach to surfaces, reagents, or other molecules in ways not intended, and this provides variability that is hard to predict.
By coating the surfaces that are exposed in the experimental systems with a protective layer, Bovine Serum Albumin can mitigate these effects. This competitive coverage prevents interactions with experimental proteins, maintaining interaction with target proteins.
It reduces random sampling and random occurrences of binding so that the process enhances consistency among tests and experimental replicas. Such a regulated setting enables quantifiable responses to reflect actual biological or chemical interactions, leading to more analytical data interpretation and enhanced experiment reliability.
5. Reliable Performance Across Research Workflows

Reproducibility is highly valued in the trustworthiness of experimental results, yet variation of reagents may lead to inconsistencies across different experiments.
In cases where the protein additives behave in an unpredictable manner, researchers frequently have to redo their experiments or change the protocol, which consumes additional time and slows down the development.
Bovine Serum Albumin helps ensure reliable performance because its structure and behavior are well known and consistent across different uses. Its stability allows it to work effectively in various experimental systems, including cell culture media, buffer solutions, and assays.
It responds predictably to changes in temperature and handling, which reduces fluctuations that could affect results. This reliability makes it easier to standardize experiments across different labs. Having such a dependable component simplifies experimental setup and allows researchers to focus on analyzing data rather than fixing variability issues.
6. Compatibility With Serum-Free Media Systems
Serum-free media systems use defined components to replace the wide support normally provided by serum. Without the right substitutes, cells can face nutrient imbalances, stress, or changes in signaling, which affect growth and function.
Bovine Serum Albumin works well in these systems because it provides key support without introducing unknown variables. It helps transport lipids, fatty acids, and other small molecules that are important for cell metabolism and membrane health.
At the same time, it reduces environmental stress in culture systems, keeping cells stable and healthy. Because it is well-defined, researchers can maintain tighter control over experimental conditions.
This makes Bovine Serum Albumin especially useful in applications that require consistent results, scalable workflows, and precise control, such as advanced research models and production systems.
7. Practical Value in Modern Laboratory Applications
Using Bovine Serum Albumin effectively depends on careful selection, preparation, and handling. Different lab experiments need different purity levels, especially when contaminants like endotoxins could affect results.
Choosing the right type ensures it works well with both cell-based studies and analytical assays. How it is handled also affects performance.
Proper storage and avoiding repeated freeze-thaw cycles keep the protein stable and functional. When used correctly, Bovine Serum Albumin fits smoothly into existing protocols without adding extra steps or complexity.
Its versatility makes it useful for a wide range of experiments, from routine assays to specialized research applications. This reliability is why it continues to be a key component in labs that prioritize consistent results, efficient workflows, and controlled experimental conditions.
Conclusion
Bovine Serum Albumin is essential in cell culture and assay experiments because it solves several common challenges at once. It helps stabilize proteins, keeps cells healthy, reduces unwanted interactions, and improves the clarity of assay results, all while performing consistently.
These benefits make experiments more reproducible and workflows easier to manage. When used carefully and handled properly, Bovine Serum Albumin increases the reliability of data without adding extra steps or complexity.
Its continued use highlights its importance as a dependable component in laboratory research, providing a solid foundation for accurate, controlled, and repeatable experimental results.







